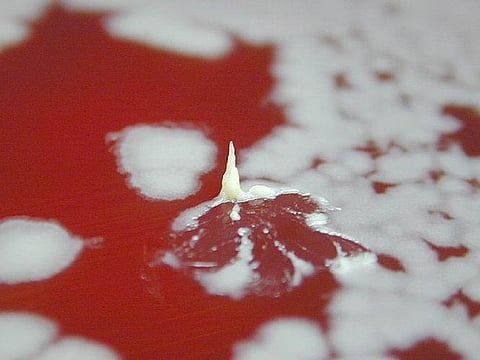

A lower level of sodium in the blood may affect cognitive functions with advancing age, a new study has warned.
Hyponatremia is a condition that occurs when the level of sodium in the blood falls below 135 Millimoles Per Litre (mmol/L).
The results indicate that sodium levels may help preserve cognition as individuals age.
"Slightly lower sodium levels in the blood are likely to be unnoticed in clinical practice," said the co-author of the study, Kristen Nowak from the University of Colorado Anschutz Medical Campus.
"Because both slightly lower serum sodium levels and mild changes in cognitive function are common occurrences with advancing age, future research on this topic is important — including determining whether correcting lower sodium levels affects cognitive function," Nowak added.
A total of 100 men had serum levels indicative of hyponatremia. Wikimedia Commons
For the study, to be published in the Clinical Journal of the American Society of Nephrology, researchers examined information on 5,435 asymptomatic community-dwelling men aged 65 years and above who were followed for a median of 4.6 years.
A total of 100 men had serum levels indicative of hyponatremia.
The researchers found that slightly lower sodium levels in the blood were related to both cognitive impairment and declines in cognitive function over time.
Compared with men with sodium levels of 141-142 mmol/L, men with levels of 126-140 mmol/L were 30 percent more likely to have cognitive impairment at baseline and 37 percent more likely to experience cognitive decline over time.
They also found an association of high serum sodium (143-153 mmol/L) with cognitive decline over time. IANS